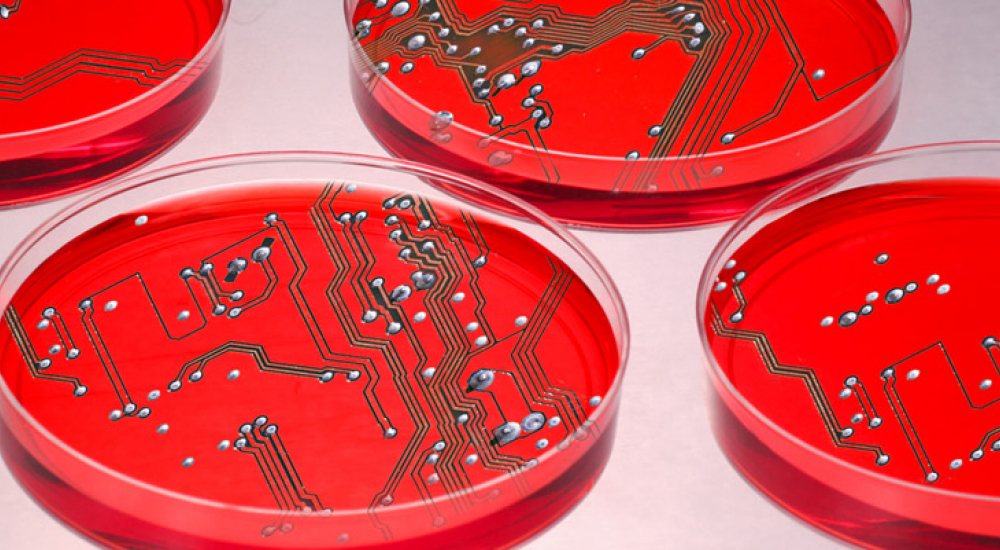

Artificial Intelligence inzetten om operationele, klinische doelen te bereiken
Het potentieel van Artificial Intelligence (AI) voor het verbeteren van de gezondheidszorg is onbegrensd, met een breed scala aan toepassingen en mogelijkheden (bijvoorbeeld op de afdeling Radiologie) van betere diagnoses tot verbeterde workflow, die zonder twijfel zullen leiden tot een verandering van de rol van de radioloog.
Vier toepassingen van AI in de gezondheidszorg
Vandaag de dag is de gezondheidszorg complexer. Door stijgende kosten(1), een wereldwijd tekort aan zorgpersoneel(2) en gebrek aan operationele efficiency staat de gezondheidszorg onder druk. Daarom is er een urgente behoefte aan hoogwaardige en efficiënte zorg. IT-managers in de gezondheidszorg beseffen dat operationele efficiëntie van cruciaal belang is, samen met de noodzaak om beter gebruik te maken van de enorme hoeveelheden gegevens die binnen alle organisaties worden verzameld.
Een tekort aan inzichten op basis van medische gegevens
Hoewel AI al tientallen jaren bestaat, staan de meeste gezondheidszorginstellingen nog maar aan het begin van hun mogelijke gebruik van deze technologie. De ontwikkeling van AI in de gezondheidszorg raakt nu in een versnelling vanwege de mogelijkheid om nuttige inzichten te leveren op basis van grote hoeveelheden gegevens. Op die manier kan het overbelaste personeel in de gezondheidszorg enorm geholpen worden.
De hoeveelheid en de mate van detail van de opgeslagen digitale medische en zorggerelateerde gegevens die onder het toezicht van een CIO vallen, zijn exponentieel toegenomen. Toch wordt nog slechts een fractie van de gegevens gebruikt om de efficiency en kwaliteit van de zorg te verbeteren. Deze gigantische toename van het volume en de diversiteit van de gegevens is een punt van zorg voor IT-managers in de zorg omdat de snelheid van de gegevensverzameling hoger is dan het vermogen om de gegevens te analyseren.
"Zorgverleningsinstellingen hebben enorme hoeveelheden gegevens, maar die leiden tot nog maar weinig inzichten", zegt Roy Smythe MD, Chief Medical Officer voor Health Informatics, Philips Healthcare. "En wat artsen eigenlijk willen, is inzichten, informatie die zij werkelijk nodig hebben. Bijvoorbeeld: wie onder de 2000 diabetespatiënten in hun patiëntenpopulatie zijn de 10 patiënten die behandeld moeten worden volgens een ander protocol? Dit zijn de inzichten waar ze naar op zoek zijn."
AI-toepassingen in de gezondheidszorg
AI heeft een onbegrensd potentieel voor het verbeteren van het gezondheidszorgsysteem. Het biedt een unieke kans om zinvolle informatie te extraheren uit klinische gegevens en zodoende een geïntegreerde gezondheidszorg mogelijk te maken die preciezer is en betere voorspellende eigenschappen heeft. Om alle aspecten van oplossingen op basis van AI te optimaliseren, is er een uitgebreide samenwerking tussen artsen, gegevenswetenschappers, interactieontwikkelaars en andere experts nodig. Hier zijn vier toepassingen van AI die de gezondheidszorg kunnen transformeren:
- Operationele efficiëntie en kwaliteit verbeteren | Op het niveau van afdelingen en organisaties kan het vermogen van AI om grote hoeveelheden gegevens door te spitten, ziekenhuisdirecties helpen de kwaliteit te optimaliseren, de productiviteit te verhogen en het gebruik van bestaande middelen te verbeteren, wat tijd- en kostenbesparingen oplevert. Op de afdeling Radiologie kan AI bijvoorbeeld verschil maken in het beheer van verwijzingen, inplannen van patiënten en voorbereiden van onderzoeken. Dergelijke verbeteringen leiden tot betere ervaringen voor patiënten en kunnen zorgen voor een effectiever en efficiënter gebruik van de faciliteiten op de onderzoekslocaties.
- Ondersteuning voor klinische besluitvorming | Oplossingen op basis van AI kunnen helpen om grote hoeveelheden klinische gegevens met elkaar te combineren om een meer holistische kijk op patiënten mogelijk te maken. Dit ondersteunt zorgverleners bij hun besluitvorming, leidt tot betere resultaten voor de patiënt en een betere gezondheid van de populatie. "Er is een enorme behoefte aan inzichten die klinische behandelingen kunnen ondersteunen”, zegt Dr. Smythe. "Of het nu gaat om de juistheid van ingrepen of het effectieve gebruik van personeel; dit zijn dingen waar artsen mee worstelen. Dat is wat er nodig is."
- De gezondheid van een populatie beheren | Als systemen ter ondersteuning van klinische besluitvorming worden gecombineerd met selfmanagement voor patiënten, kan de gezondheid van een populatie ook verbeteren door AI. Door gebruik te maken van voorspellende analyses voor een patiëntpopulatie kunnen zorgverleners preventieve actie ondernemen, gezondheidsrisico's verminderen en daardoor onnodige kosten voorkomen. Naarmate de leeftijd van een populatie stijgt, neemt ook de wens toe om waar mogelijk onafhankelijk te blijven wonen en niet alleen ziektebestrijding te optimaliseren, maar ook kwaliteit van leven te bevorderen. Door de mogelijkheid om medische gegevens van miljoenen consumenten te verzamelen, analyseren en activeren kunnen ziekenhuizen inschatten hoe socio-economische, gedrags-, genetische en klinische factoren met elkaar correleren en kan een doelgerichtere, preventieve zorg mogelijk worden gemaakt buiten de muren van het ziekenhuis.
- Consumenten emanciperen, patiëntenzorg verbeteren | Nog in 2015 vertelden patiënten dat ze van de ene spreekkamer van een arts naar de andere moesten lopen met hun röntgenfoto's, testresultaten en andere kritische medische gegevens onder de arm(3). Meervoudige verwijzingen, waarbij patiënten steeds weer hun symptomen uit de doeken moesten doen bij een nieuwe arts waarna weer werd geconstateerd dat er hiaten waren in de medische geschiedenis, vormden een reëel probleem. Vandaag de dag verwachten patiënten zorg die persoonlijker, beter op hen afgestemd en prettiger is.
Het belangrijkste motief achter AI is dat naarmate patiënten beter geïnformeerd en mondiger worden over hun gezondheid en een beter begrip ontwikkelen van wat ze willen, de gezondheidszorg hun meer tegemoet moet komen en zorg moet verlenen wanneer ze die nodig hebben, niet alleen wanneer ze ziek zijn.
1 US Centers for Medicare & Medicaid Services
2 WHO, 'Global health workforce shortage to reach 12.9 million in coming decades'
3 HBR, 'Giving Patients an Active Role in Their Health Care'
Artificial Intelligence | Revolutie van de 21ste eeuw
De razendsnelle ontwikkeling van AI is een van de meest impactvolle ontwikkelingen van deze tijd. Er worden grote stappen gezet bij de evolutie van lerende algoritmes en het probleemoplossend vermogen van AI en deze technologie wordt steeds beter toepasbaar binnen bedrijfsprocessen. Het gebruik van AI in het bedrijfsleven groeit sterk, ook bij onze leden. Om de kansen en mogelijkheden van Artificial Intelligence in de technologische industrie optimaal te verzilveren, heeft FME het Platform 'AI for Industry' opgericht. We verbinden in dit platform leden die AI ontwikkelen en toepassen – of dat overwegen te doen – met elkaar.
Lees meer over het FME-platform 'AI for Industry'